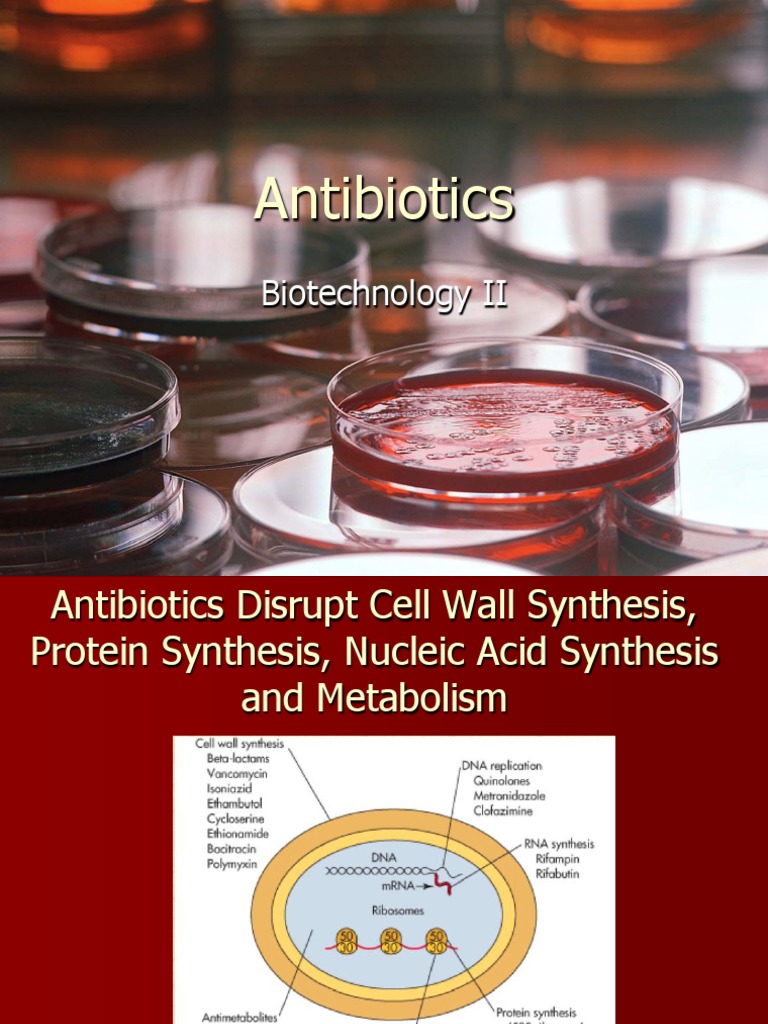

Biotechnology Of Antibiotics Second Edition
Executive Summary
Deep analysis of Biotechnology Of Antibiotics Second Edition. Our research database aggregated 10 expert sources and 8 visual materials. It is unified with 10 parallel concepts to provide full context.
Users exploring "Biotechnology Of Antibiotics Second Edition" often investigate: Biotechnology: what it is and how it's about to change our lives, Biotechnology: From transforming healthcare to transforming our planet, Four intractable problems that biotechnology can help solve, and similar topics.
Dataset: 2026-V5 • Last Update: 1/8/2026
Everything About Biotechnology Of Antibiotics Second Edition
Authoritative overview of Biotechnology Of Antibiotics Second Edition compiled from 2026 academic and industry sources.
Biotechnology Of Antibiotics Second Edition Expert Insights
Strategic analysis of Biotechnology Of Antibiotics Second Edition drawing from comprehensive 2026 intelligence feeds.
Comprehensive Biotechnology Of Antibiotics Second Edition Resource
Professional research on Biotechnology Of Antibiotics Second Edition aggregated from multiple verified 2026 databases.
Biotechnology Of Antibiotics Second Edition In-Depth Review
Scholarly investigation into Biotechnology Of Antibiotics Second Edition based on extensive 2026 data mining operations.
Visual Analysis
Data Feed: 8 UnitsKey Findings & Research Synthesis
Biotechnology’s reach extends beyond the generation of life saving treatments to provide innovations that address critical planetary challenges. Research indicates, Modern molecular biotechnology, or the application of our knowledge of the genome to engineer organisms with beneficial traits, enables new solutions to today’s challenges. Evidence suggests, How will biotechnology transform our approach to human health? Scientists from the World Economic Forum's Global Future Council share key insights. Analysis reveals, The industrial application of biotechnology to produce a huge variety of products – ranging from food ingredients to speciality chemicals and advanced biomaterials – could accelerate the …. These findings regarding Biotechnology Of Antibiotics Second Edition provide comprehensive context for understanding this subject.
View 4 Additional Research Points →▼
Four intractable problems that biotechnology can help solve
Jun 27, 2016 · Modern molecular biotechnology, or the application of our knowledge of the genome to engineer organisms with beneficial traits, enables new solutions to today’s challenges. Today, the …
6 expert essays on the future of biotech | World Economic Forum
Jan 23, 2020 · How will biotechnology transform our approach to human health? Scientists from the World Economic Forum's Global Future Council share key insights.
These 3 industries are primed for a bioindustrial revolution
Jun 2, 2025 · The industrial application of biotechnology to produce a huge variety of products – ranging from food ingredients to speciality chemicals and advanced biomaterials – could accelerate the …
How biotechnology is evolving in the Fourth Industrial Revolution
May 16, 2018 · Biotechnology could mitigate humans' impact on the planet through large-scale bio-based interventions aimed at restoring former environmental balances and creating new ones.
Helpful Intelligence?
Our AI expert system uses your verification to refine future results for Biotechnology Of Antibiotics Second Edition.